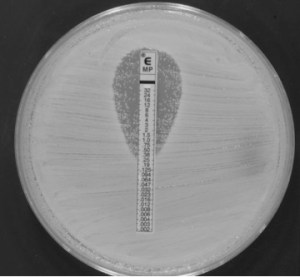

Comentarios recientes
- Martha en ¿Por qué?
- Blanca Rosa MAYORCA de PAREDES en ¿Cómo actúan los antibióticos?: Mecanismos de acción
- José María Cuadrado en Réplica a “Trade-off, información veraz y decisiones óptimas en tiempos de COVID”
- Salvador Pérez Cortés en Réplica a “Trade-off, información veraz y decisiones óptimas en tiempos de COVID”

últimas noticias
- Medicina personalizada de precisión (MPP) en enfermedades infecciosas: explotemos el antibiograma
- Réplica a “Trade-off, información veraz y decisiones óptimas en tiempos de COVID”
- Recopilación de artículos y noticias Covid-19 #HCUZ. Semana 26/2021 (21J-27J)
- Recopilación de artículos y noticias Covid-19 #HCUZ. Semana 25/2021 (14J-20J)
- Recopilación de artículos y noticias Covid-19 #HCUZ. Semana 24/2021 (7J-13J)
Deja un comentario